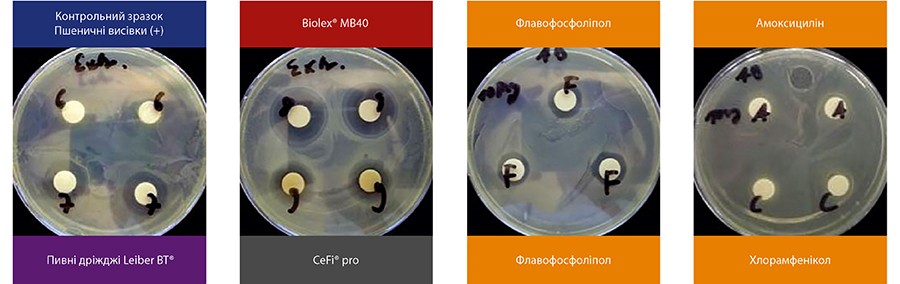
Image

Мінімізація або повне виключення антибіотиків з циклу вирощування птиці та тварин з метою отримання безпечної, чистої продукції для харчування людей, як пріоритетний напрямок розвитку технології, спонукали нас планомірно виводити на споживчий ринок України інноваційні продукти для кормової галузі, що не мають аналогів і спрямовані на підвищення продуктивності та зміцнення здоров'я тварин. Один з найцікавіших продуктів, які вже представлені у нас в країні - екстракт пивних дріжджів з мультибіотичною дією Biolex®-MB 40 виробництва німецької компанії «Leiber».
Даний продукт визнаний фахівцями в усьому світі і є мультибіотиком, має 4 дії: бактерицидну, антибіотичну, пробіотичну, інактивує відомі мико- та ендотоксини (похідні клостридії, кишкової палочки т.д.).
Biolex®-MB40 містить гарантовану кількість 1,3-1,6 β-глюканів, є імуномодулятором, певний рівень маннанолігосахаридів, а також містить через бродіння хмелю дуже важливі α- і β-кислоти, що діють антибіотично, астрінгентно, тобто в цьому продукті всі складові строго підібрані, сінергіруя дію один одного, за рахунок чого він і є мультибіотиком.
Маючи багатий досвід в області виробництва дріжджових продуктів, німецька компанія «Leiber» використовує тільки першокласну сировину з пивоварень Німеччини і Європи, які працюють в системі «чистого виробництва».
Вільна від GMO, що не має сторонніх добавок сировина являє собою виключно 100% солодовий субстрат, жорстко контрольований по чистоті.
Biolex®-MB40 отримують саме з розчинного екстракту пивних дріжджів. При цій технології певні сегменти клітинних стінок фракціонують, а пурини і нуклеїнові кислоти відокремлюються. Biolex®-MB40 є екстрагованим продуктом, має потужний зв'язок з адсорбуючим ефектом. Але необроблені дріжджі такими властивостями не володіють.
Рисунки 1-4. Інгібуючий ефект антибіотиків та пивних дріжджів у живильному середовищі з Staphylococcus aureus
Таблиця. Інгібуючий ефект різних антибіотиків та зразків пивних дріжджів (зона затримки росту, мм)

Чому у виробництві Biolex®-MB 40 використовуються саме пивні дріжджі?
Пивні дріжджі - це природний продукт з дуже високою концентрацією органічно пов'язаних біологічно активних речовин. До них відносяться вітаміни групи B, мікроелементи, ензими, нуклеїнові кислоти, а також нуклеотиди і нуклеозиди - будівельні блоки нуклеїнових кислот.
Крім цього, клітинна стінка пивних дріжджів штаму Saccharmyces cerevisiae містить специфічні β-глюкани, які здатні активувати захисні механізми організму стосовно патогенних мікроорганізмів.
Маннанолігосахариди, завдяки своїм пребіотичним властивостями, ефективно підтримують баланс мікрофлори кишечника. У клітинах пивних дріжджів міститься бактеріальний агент Malucidin, який в процесі ферментації захищає дріжджові клітини від впливу конкурентів - інших видів дріжджів (Candida, Torula) і деяких видів бактерій, наприклад, сальмонели. Останні дослідження показали, що речовини, що містяться в хмелі, надають пивним дріждям додаткові інгібуючі властивості щодо патогенних мікроорганізмів.
Проведені компанією TeLA GmbH (Бремерхафен) дослідження антибіотиків і компонентів пивних дріжджів також підтвердили, що пивні дріжджі мають бактеріостатичну дію.
Компоненти хмелю згідно з офіційним методом були екстрагованих з різних препаратів пивних дріжджів і досліджені на предмет інгібуючої дії щодо тестштамма золотистого стафілокока Staphylococcus aureus ATCC6538P.
У розведеному вигляді (1:10) розчини від негативного контролю (висівки), 3 позитивних контролі (хлорамфенікол, амоксицилін, флавофосфоліпол), а також контрольні зразки - пивні дріжджі Leiber BT®, CeFi® pro і Biolex®-МB40 - на дисках з антибіотиками були розміщені в живильному середовищі в ємностях для ферментації з Staphylococcus aureus.
Наведені нижче таблиця і малюнки показують неповне пригнічення на тлі зниження / гальмування зростання (каламутна зона) і, відповідно, повне інгібування - в межах прозорої зони в залежність від обробки, діаметр зони затримки росту, мм (в цифровій формі).
